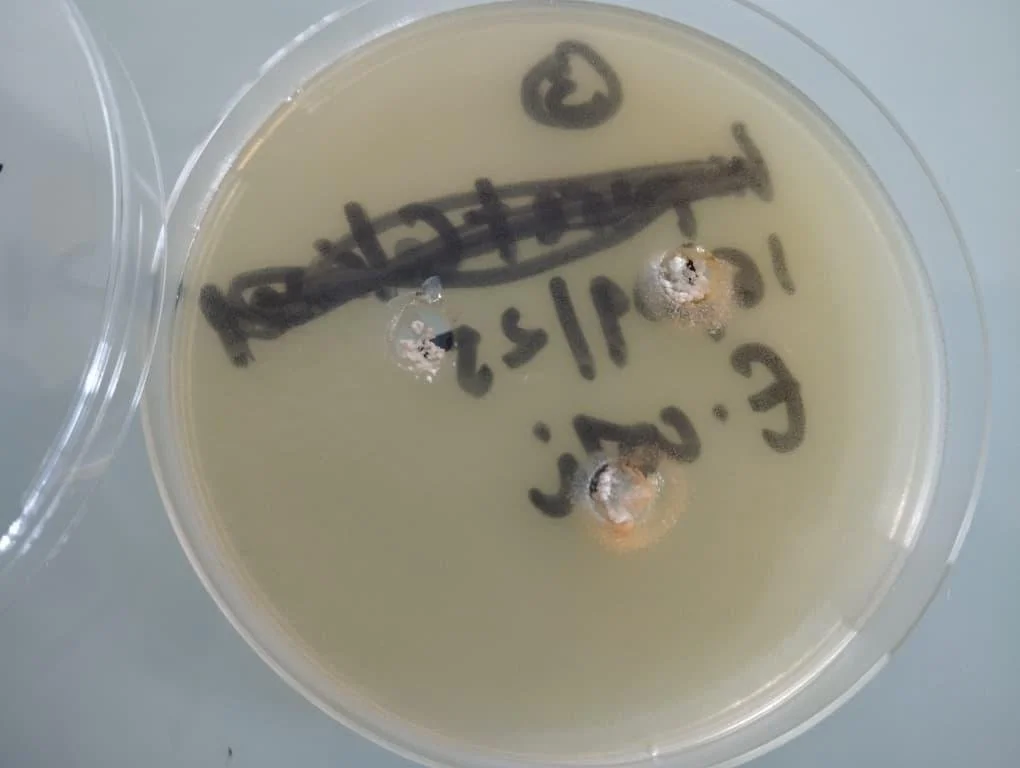
Sei E.coli inhibition test proving antibacterial properties

We’re all familiar with threads,
but rarely think about the fiber behind them
Sei™

A nano-structured marine material designed for strength and flexibility. Sei™ is made from marine biomass - Algae - and has several applications ranging from textile fibers, to coated canvas, and more.

SeiFibre™ is produced through wet spinning: a manufacturing process in which polymers are extruded into fibers.
SeiFibre™ is a staple fiber produced through extrusion. In its natural state, the fiber appears off-white, as shown in the white petri dish below. Pigment trials have been conducted using natural pigments (blue petri dish) as well as through a dope-dyeing technique, illustrated in the grey petri dish.

Anti-bacterial

Petri dish with Sei™ inhibiting the growth of E. Coli bacteria culture, showing anti-bacterial activity.

A unique formula at the intersection of biotech and design
Science
Exceptional tech qualities
Advanced textile engineering
New formulation and process IP protected by 2 patents
Material
Industry fluency
Differentiating branding
Unique design
Design
Why we’re built to scale what others can’t

Featured partner: Inovafil, PortugalTech compatibility
Our tech is compatible with existing processes and machineryNo CAPEX
No need to build new facilitiesReliable inputs
Reliance on abundant resources, easy to source consistentlyCost-competitive at scale
Competitive pricing17
Fabrics
manufacturers
09
Yarn
spinners
03
Fiber
producers
29
Partners
510.000lm
Production capacity per year
7.000lm
Pre-ordered through our platform (Y1)
What our partners guarantee
Efficient & optimized production processesAbility to scale with existing capacityConsistent production over timeReliable & high-quality production outputMaterial applications

What’s next
We are currently expanding our R&D efforts to explore new color possibilities through marine-based natural dyes, and to investigate how marine biomass can deliver rich, durable, and responsible coloration. In parallel, we are developing dope-dyed versions, integrating color directly into the fiber during production to achieve long-lasting colorfastness, as well as enhanced resistance to heat and light, while remaining fully aligned with our material philosophy.

Petri dishes with natural dyes experiments

Petri dish with carbon dope-dyeing test















